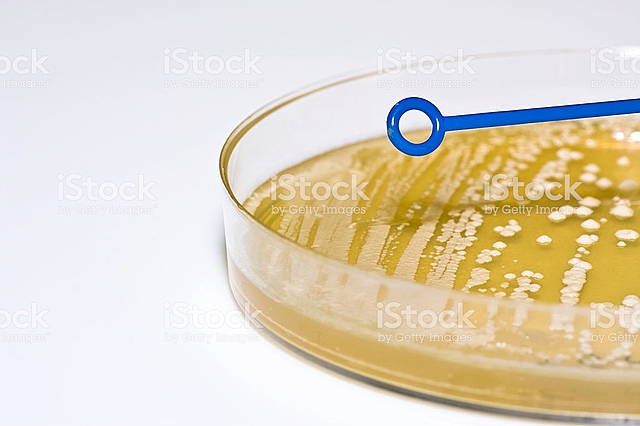
AGAR-AGAR

-
Zacharias Janssen inventó el microscopio compuesto conformado por un tubo de 70 cm de largo y 9 cm de diametro con una lente convexa en cada extremo
-
Robert hooke descubrió la célula observando en el microscopio una lamina de corcho dándose cuenta que estaba formada por pequeñas cavidades poliédricas que parecían celdillas de un panal
-
Anton van leewenhoek descubrió los microorganismos a los que llamó animalucos formas de vidas que observó en agua
-
Carl Linnaeus creó un sistema de nomenclatura binomial para clasificar a los seres vivos
-
Lazzaro spallanzani propuso que el aire transportaba germenes al medio del cultivo
-
Edward jenner descubrió la vacuna antivariolítica que tuvo trascendencia definitoria para combatir la viruela, enfermedad que se había convertido en una terrible epidemia en varios continentes
-
Theodor schwann demostró la gran barrera entre los reinos animal y vegetal. Acuñó el termino "metabolismos" descubrió las células vegetales y propuso una teoría de la célula que estaba seguro que era la clave para la anatomía y el crecimiento de las plantas.
-
Louis Pasteur refutó la teoría de la generación espontanea, hizo estudios sobre fermentación alcohólica e implementa procesos de esterilización.
-
Ernest Heackel crea un taxón denominado monores para agrupar las bacterias. Precursor de la división entre los seres procariotas y eucariotas
-
Robert koch fue el primero en aislar microorganismos, descubrió el bacilo de la tuberculosis, es considerado el fundador de la bacteriología
-
John Tyndall confirmó la teoría de la biogénesis, aplicó la esterilización por calentamiento descontinuo, evidenció la existencia de formas microbacterianas por reposo, muy resistentes al calor
-
Walther y Angelina Hesse surgió el agar como como una sustancia ideal para medio de cultivo
-
Julius petri inventó la placa petri, esta se utiliza en os laboratorios principalmente para el cultivo de microorganismos, soliendose cubrir el fondo con distintos medios sólidos de cultivo según el microorganismo que se quiera cultivar
-
Max delbruck publicó un artículo en el que se enunciaba una ecuación que describía la relación de mutación en cultivos de bacterias, entre las susceptibilidades y las resistencias
-
James watson y Francis Crik descubrieron la estructura molecular del DNA, la estructura de la molécula en doble hélice que es el ADN dio al mundo la llave para entender todos los secretos de la vida
-
la comunidad científica consideró a Stanley prusiner un hereje por defender la existencia de un nuevo agente infeccioso: el prion, una proteína sin material genético causante de enfermedades
Want to make a timeline like this?
Use Timetoast to turn dates, events, milestones, and phases into a clear visual timeline you can build and share. Timetoast is a timeline maker for work, school, research, and stories.